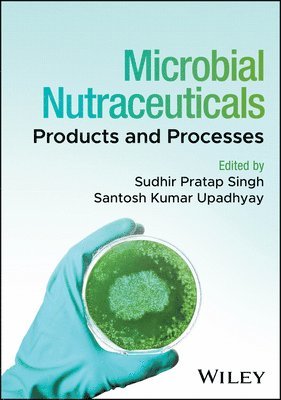

Sudhir Pratap Singh – författare
2 386 kr
Skickas inom 10-15 vardagar
2 758 kr
Läs direkt efter köp
2 758 kr
Läs direkt efter köp
2 473 kr
Läs direkt efter köp
Discover a comprehensive and current overview of microbial bioprospecting written by leading voices in the field
In Bioprospecting of Microorganism-Based Industrial Molecules, distinguished researchers and authors Sudhir P. Singh and Santosh Kumar Upadhyay deliver global perspectives of bioprospecting of biodiversity. The book covers diverse aspects of bioprospecting of microorganisms demonstrating biomass value of nutraceutical, pharmaceutical, biomedical, and bioenergetic importance.
The authors present an amalgamation of translational research on bioresource utilization and ecological sustainability that will further the reader’s knowledge of the applications of different microbial diversity and reveal new avenues of research investigation.
Readers will also benefit from:
A thorough introduction to microbial biodiversity and bioprospecting An exploration of anti-ageing and skin lightening microbial products and microbial production of anti-cancerous biomolecules A treatment of UV protective compounds from algal biodiversity and polysaccharides from marine microalgal sources Discussions of microbial sources of insect toxic proteins and the role of microbes in bio-surfactants productionPerfect for academics, scientists, researchers, graduate and post-graduate students working and studying in the areas of microbiology, food biotechnology, industrial microbiology, plant biotechnology, and microbial biotechnology, Bioprospecting of Microorganism-Based Industrial Molecules is an indispensable guide for anyone looking for a comprehensive overview of the subject.
2 206 kr
Skickas inom 5-8 vardagar
2 473 kr
Läs direkt efter köp
BIOPROSPECTING OF PLANT BIODIVERSITY FOR INDUSTRIAL MOLECULES
A comprehensive collection of recent translational research on bioresource utilization and ecological sustainability
Bioprospecting of Plant Biodiversity for Industrial Molecules provides an up-to-date overview of the ongoing search for biodiverse organic compounds for use in pharmaceuticals, bioceuticals, agriculture, and other commercial applications. Bringing together work from a panel of international contributors, this comprehensive monograph covers natural compounds of plants, endophyte enzymes and their applications in industry, plant bioprospecting in cosmetics, marine bioprospecting of seaweeds, and more.
Providing global perspectives on bioprospecting of plant biodiversity, the authors present research on enzymes, mineral micro-nutrients, biopesticides, algal biomass, and other bioactive molecules. In-depth chapters assess the health impacts and ecological sustainability of the various biomolecules and identify existing and possible applications ranging from ecological restoration to production of essential oils and cosmetics. Other topics include, bio-energy crops as alternative fuel resources, the role of plants in phytoremediation of industrial waste, and the industrial applications of endophyte enzymes.
This comprehensive resource:
Includes a through introduction to plant biodiversity and bioprospecting Will further the knowledge of application of different plants and improve research investigation techniques. Summarizes novel approaches for researchers in food science, microbiology, biochemistry, and biotechnologyBioprospecting of Plant Biodiversity for Industrial Molecules is an indispensable compendium of biological research for scientists, researchers, graduate and postgraduate students, and academics in the areas of microbiology, food biotechnology, industrial microbiology, plant biotechnology, and microbial biotechnology.
2 473 kr
Läs direkt efter köp
BIOPROSPECTING OF PLANT BIODIVERSITY FOR INDUSTRIAL MOLECULES
A comprehensive collection of recent translational research on bioresource utilization and ecological sustainability
Bioprospecting of Plant Biodiversity for Industrial Molecules provides an up-to-date overview of the ongoing search for biodiverse organic compounds for use in pharmaceuticals, bioceuticals, agriculture, and other commercial applications. Bringing together work from a panel of international contributors, this comprehensive monograph covers natural compounds of plants, endophyte enzymes and their applications in industry, plant bioprospecting in cosmetics, marine bioprospecting of seaweeds, and more.
Providing global perspectives on bioprospecting of plant biodiversity, the authors present research on enzymes, mineral micro-nutrients, biopesticides, algal biomass, and other bioactive molecules. In-depth chapters assess the health impacts and ecological sustainability of the various biomolecules and identify existing and possible applications ranging from ecological restoration to production of essential oils and cosmetics. Other topics include, bio-energy crops as alternative fuel resources, the role of plants in phytoremediation of industrial waste, and the industrial applications of endophyte enzymes.
This comprehensive resource:
Includes a through introduction to plant biodiversity and bioprospecting Will further the knowledge of application of different plants and improve research investigation techniques. Summarizes novel approaches for researchers in food science, microbiology, biochemistry, and biotechnologyBioprospecting of Plant Biodiversity for Industrial Molecules is an indispensable compendium of biological research for scientists, researchers, graduate and postgraduate students, and academics in the areas of microbiology, food biotechnology, industrial microbiology, plant biotechnology, and microbial biotechnology.
2 111 kr
Skickas inom 5-8 vardagar
2 473 kr
Läs direkt efter köp
Discover a comprehensive and current overview of microbial bioprospecting written by leading voices in the field
In Bioprospecting of Microorganism-Based Industrial Molecules, distinguished researchers and authors Sudhir P. Singh and Santosh Kumar Upadhyay deliver global perspectives of bioprospecting of biodiversity. The book covers diverse aspects of bioprospecting of microorganisms demonstrating biomass value of nutraceutical, pharmaceutical, biomedical, and bioenergetic importance.
The authors present an amalgamation of translational research on bioresource utilization and ecological sustainability that will further the reader’s knowledge of the applications of different microbial diversity and reveal new avenues of research investigation.
Readers will also benefit from:
A thorough introduction to microbial biodiversity and bioprospecting An exploration of anti-ageing and skin lightening microbial products and microbial production of anti-cancerous biomolecules A treatment of UV protective compounds from algal biodiversity and polysaccharides from marine microalgal sources Discussions of microbial sources of insect toxic proteins and the role of microbes in bio-surfactants productionPerfect for academics, scientists, researchers, graduate and post-graduate students working and studying in the areas of microbiology, food biotechnology, industrial microbiology, plant biotechnology, and microbial biotechnology, Bioprospecting of Microorganism-Based Industrial Molecules is an indispensable guide for anyone looking for a comprehensive overview of the subject.
2 002 kr
Skickas inom 5-8 vardagar
2 244 kr
Läs direkt efter köp
Harness the planet’s most numerous resources with this comprehensive guide
Microorganisms constitute the invisible majority of all living creatures on Earth. They are found virtually everywhere on the planet, including in environments too extreme for any larger organisms to exist. They form a hugely significant resource whose potential value for human society cannot be overlooked. The creation of microorganism- based bioreactors for the industrial production of valuable biomolecules has the potential to revolutionize a range of industries and fields.
Microbial Bioreactors for Industrial Molecules provides a comprehensive introduction to these bioresources. It covers all potential approaches to the use of microbial technology and the production of high-value biomolecules for the pharmaceutical, cosmetic, and agricultural industries, among others. The book’s rigorous detail and global, holistic approach to harnessing the power of the planetary microbiome make it an invaluable introduction to this growing area of research and production.
Readers will also find:
Detailed coverage of basic, applied, biosynthetic, and translational approaches to the use of microbial technology Discussion of industrially produced microbe-borne enzymes including invertase, lipase, keratinase, protease, and more Approaches for using microbial bioreactors to generate biofuelsMicrobial Bioreactors for Industrial Molecules is essential for scientists and researchers in microbiology and biotechnology, as well as for professionals in the biotech industries and graduate students studying the applications of the life sciences.
2 244 kr
Läs direkt efter köp
Harness the planet’s most numerous resources with this comprehensive guide
Microorganisms constitute the invisible majority of all living creatures on Earth. They are found virtually everywhere on the planet, including in environments too extreme for any larger organisms to exist. They form a hugely significant resource whose potential value for human society cannot be overlooked. The creation of microorganism- based bioreactors for the industrial production of valuable biomolecules has the potential to revolutionize a range of industries and fields.
Microbial Bioreactors for Industrial Molecules provides a comprehensive introduction to these bioresources. It covers all potential approaches to the use of microbial technology and the production of high-value biomolecules for the pharmaceutical, cosmetic, and agricultural industries, among others. The book’s rigorous detail and global, holistic approach to harnessing the power of the planetary microbiome make it an invaluable introduction to this growing area of research and production.
Readers will also find:
Detailed coverage of basic, applied, biosynthetic, and translational approaches to the use of microbial technology Discussion of industrially produced microbe-borne enzymes including invertase, lipase, keratinase, protease, and more Approaches for using microbial bioreactors to generate biofuelsMicrobial Bioreactors for Industrial Molecules is essential for scientists and researchers in microbiology and biotechnology, as well as for professionals in the biotech industries and graduate students studying the applications of the life sciences.
1 925 kr
Skickas inom 5-8 vardagar
2 244 kr
Läs direkt efter köp
An incisive and practical discussion of how to use plants as bioreactors
In Plants as Bioreactors for Industrial Molecules, a team of distinguished researchers delivers an insightful and global perspective on the use of plants as bioreactors. In the book, you’ll find coverage of the basic, applied, biosynthetic, and translational approaches to the exploitation of plant technology in the production of high-value biomolecules. The authors focus on the yield and quality of amino acids, vitamins, and carbohydrates.
The authors explain how high-value biomolecules enable developers to create cost-effective biological systems for the production of biomolecules useful in a variety of sectors. They provide a holistic approach to plant-based biological devices to produce natural molecules of relevance to the health and agriculture industries.
Readers will also find:
A thorough overview of plants as bioreactors and discussions of molecular farming for the production of pharmaceutical proteins in plants Comprehensive explorations of plants as edible vaccines and plant cell culture for biopharmaceuticals Practical discussions of the production of attenuated viral particles as vaccines in plants and insecticidal protein production in transgenic plants Extensive treatment of the regulatory challenges involved in using plants as bioreactorsPerfect for academics, scientists, and researchers in industrial microbiology and biotechnology, Plants as Bioreactors for Industrial Molecules will also earn a place in the libraries of biotechnology company professionals in applied product development.
2 244 kr
Läs direkt efter köp
An incisive and practical discussion of how to use plants as bioreactors
In Plants as Bioreactors for Industrial Molecules, a team of distinguished researchers delivers an insightful and global perspective on the use of plants as bioreactors. In the book, you’ll find coverage of the basic, applied, biosynthetic, and translational approaches to the exploitation of plant technology in the production of high-value biomolecules. The authors focus on the yield and quality of amino acids, vitamins, and carbohydrates.
The authors explain how high-value biomolecules enable developers to create cost-effective biological systems for the production of biomolecules useful in a variety of sectors. They provide a holistic approach to plant-based biological devices to produce natural molecules of relevance to the health and agriculture industries.
Readers will also find:
A thorough overview of plants as bioreactors and discussions of molecular farming for the production of pharmaceutical proteins in plants Comprehensive explorations of plants as edible vaccines and plant cell culture for biopharmaceuticals Practical discussions of the production of attenuated viral particles as vaccines in plants and insecticidal protein production in transgenic plants Extensive treatment of the regulatory challenges involved in using plants as bioreactorsPerfect for academics, scientists, and researchers in industrial microbiology and biotechnology, Plants as Bioreactors for Industrial Molecules will also earn a place in the libraries of biotechnology company professionals in applied product development.
2 111 kr
Skickas inom 5-8 vardagar
2 366 kr
Läs direkt efter köp
An exploration of the latest advances in the application of microbial nutraceuticals in healthcare, food production, and agriculture
In Microbial Nutraceuticals: Products and Processes, a team of distinguished researchers delivers an up-to-date and authoritative discussion of the recent advances in the application of microbial nutraceuticals and their implementation in the health, food, and agriculture sectors. The book begins with an overview of microbial nutraceuticals before moving on to discussions of more specific topics, including microbial cell factories for the production of essential amino acids, microbial production of dietary short-chain fatty acids, and microbial sources for bioactive peptides conferring health benefits.
Readers will also find:
A thorough introduction to symbiotic products with nutraceutical impactComprehensive explorations of postbiotic supplements with nutraceutical significancePractical discussions of microbial production of carotenoidsComplete treatments of microbial engineering for multivitamin productionThis book is intended for academics, scientists, and researchers working in the field of microbial nutraceuticals. Additionally, it will benefit professionals working in the agri-biotech industries, as well as graduate and post-graduate students with an interest in the subject.
2 366 kr
Läs direkt efter köp
An exploration of the latest advances in the application of microbial nutraceuticals in healthcare, food production, and agriculture
In Microbial Nutraceuticals: Products and Processes, a team of distinguished researchers delivers an up-to-date and authoritative discussion of the recent advances in the application of microbial nutraceuticals and their implementation in the health, food, and agriculture sectors. The book begins with an overview of microbial nutraceuticals before moving on to discussions of more specific topics, including microbial cell factories for the production of essential amino acids, microbial production of dietary short-chain fatty acids, and microbial sources for bioactive peptides conferring health benefits.
Readers will also find:
A thorough introduction to symbiotic products with nutraceutical impactComprehensive explorations of postbiotic supplements with nutraceutical significancePractical discussions of microbial production of carotenoidsComplete treatments of microbial engineering for multivitamin productionThis book is intended for academics, scientists, and researchers working in the field of microbial nutraceuticals. Additionally, it will benefit professionals working in the agri-biotech industries, as well as graduate and post-graduate students with an interest in the subject.
2 018 kr
Skickas inom 5-8 vardagar
2 366 kr
Läs direkt efter köp
Holistic approach to the herbal aspects of nutraceuticals and their implementation in the health and agriculture sectors
Herbal Nutraceuticals: Products and Processes delivers comprehensive coverage of the herbal aspects of nutraceuticals along with their many applications in the health and agriculture sectors. The book begins with an overview of plant-based nutraceuticals and the role of plant biotechnology in nutraceutical production. Each chapter covers a unique topic related to nutraceuticals and the positive and negative implications associated with each substance discussed. The text concludes by addressing safety concerns associated with microalgal nutraceuticals and discussing toxicity evaluation of nutraceuticals overall.
Written by two academics with significant experience in the field, Herbal Nutraceuticals: Products and Processes includes information on:
Significance of nutraceuticals in modern health maintenance and disease prevention, and applications of spices in nutraceuticals Antioxidant properties and anti-ageing potential of food plants, beverages such as herbal wine, and nutraceuticals Nutraceuticals with anti-diabetic, anti-inflammatory, and anti-carcinogenic potentials, and sources, medicinal properties, and applications of carotenoids in food and the nutraceutical industry Nutraceuticals in legumes, herbal beverages, edible oils, conventional and nonconventional fruits, staple food crops, and pseudocerealsHerbal Nutraceuticals: Products and Processes is an essential up-to-date reference on the subject for academics and researchers, as well as professionals and research institutions involved in agri-biotech product development.
2 366 kr
Läs direkt efter köp
Holistic approach to the herbal aspects of nutraceuticals and their implementation in the health and agriculture sectors
Herbal Nutraceuticals: Products and Processes delivers comprehensive coverage of the herbal aspects of nutraceuticals along with their many applications in the health and agriculture sectors. The book begins with an overview of plant-based nutraceuticals and the role of plant biotechnology in nutraceutical production. Each chapter covers a unique topic related to nutraceuticals and the positive and negative implications associated with each substance discussed. The text concludes by addressing safety concerns associated with microalgal nutraceuticals and discussing toxicity evaluation of nutraceuticals overall.
Written by two academics with significant experience in the field, Herbal Nutraceuticals: Products and Processes includes information on:
Significance of nutraceuticals in modern health maintenance and disease prevention, and applications of spices in nutraceuticals Antioxidant properties and anti-ageing potential of food plants, beverages such as herbal wine, and nutraceuticals Nutraceuticals with anti-diabetic, anti-inflammatory, and anti-carcinogenic potentials, and sources, medicinal properties, and applications of carotenoids in food and the nutraceutical industry Nutraceuticals in legumes, herbal beverages, edible oils, conventional and nonconventional fruits, staple food crops, and pseudocerealsHerbal Nutraceuticals: Products and Processes is an essential up-to-date reference on the subject for academics and researchers, as well as professionals and research institutions involved in agri-biotech product development.